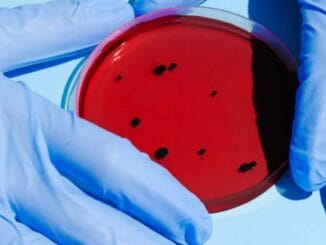

ABD’nin Texas eyaletinde bir nehir yatağında, nehirin aşırı kuraklıkta kuruması üzerine 113 milyon yıl önceden kalma dinozor ayak izleri ortaya çıktı.
Dev ayak izlerinin tek bir Acrocanthosaurus’a ait olduğu tahmin ediliyor. En son 2000 yılında görülen ayak izleri genelde suların altında, hatta toprağın da birkaç katman altında bulunuyor.
Texas Dinozor Vadi Devlet Parkı, dünyada bu tip izlerin en iyi korunduğu alanlardan biri.
ABD Kuraklık İzleme Merkezi’ne göre bu yıl Texas’ın neredeyse tümünde ciddi bir kuraklık var. Geçen hafta eyaletin yüzde 87’sinde aşırı, çok ileri ya da ileri boyutta alarm durumları ilan edildi. Bu yaz normale göre daha da kurak geçince, Texas’taki parkın ortasından geçen nehir neredeyse tamamen kurudu. Böylece dinozor ayak izleri de görülmüş oldu.
Park müfettişi Jeff Davis, BBC’ye yaptığı açıklamada, ortaya çıkan izlerin “Yalnız muhafızın ayak izleri” olarak adlandırıldığını; boyları 11 metreyi bulan Acrocanthosaurus türünde bir dinozorun bu yolda yürüdüğünü; 140 adet ayak izinden 60’ının şu an görülebilir durumda olduğunu söyledi.
Bir teropod türü olan Acrocanthosauruslar, üç tırnaklı ve yaklaşık 7 ton ağırlığındaki dinozorlardan.
Aşırı hava olayları başka şaşırtıcı olaylara da yol açtı.
ABD’nin en büyük rezervuarlarından Mead Gölü’nün de kuruması ve su seviyesinin düşmesiyle birlikte cansız insan bedenlerine ulaşıldı.
Dünya üzerinde görülen kuraklıkların tümünün sebebi iklim değişikliği olmayabiliyor. Ancak atmosferdeki aşırı sıcaklar, kuraklığı daha da hızlandırıyor ve daha kötü bir duruma getiriyor.
Dünya’daki sıcaklık, sanayi çağının başlamasından bu yana 1,2 derece arttı. Sıcaklık artmaya devam ediyor. Karbon emisyonunun azaltılması için adım atılmazsa, sıcaklık artışı daha büyük krizler doğurabilir.

İlk yorum yapan olun